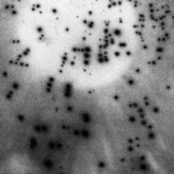
Suspended In A Stasis Field

Loading details…
Artist
François X
12+ albums
technoelectronicminimal technofrancejungle
about
With relentless construction, a strong and righteous attitude, Francois x evolves quietly in his shed. Blending true-to-the-roots with a contemporary vision of music, there is not much to add, Just always pushing things forward, looking ahead, and most of all things, staying deep. A low profile attitude. User-contributed text is available under the Creative Commons By-SA License; additional terms may apply.